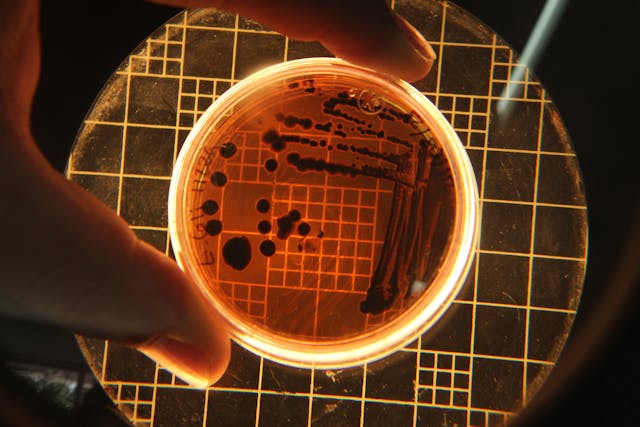

Mantener tu hogar limpio y ordenado no tiene por qué ser una tarea difícil. Con las estrategias adecuadas, lograrás una limpieza más eficiente y efectiva, utilizando productos caseros y naturales. A continuación, te ofrecemos una guía completa para mejorar tu rutina de limpieza diaria.
¿Por Qué Es Importante la Limpieza del Hogar?
Un hogar limpio no solo mejora la estética del espacio, sino que también contribuye a la salud de sus habitantes. El polvo, la suciedad y los ácaros pueden afectar la calidad del aire y provocar alergias, y producir estrés por lo que una limpieza regular es esencial para crear un entorno saludable.

Tipos de suciedad común en el hogar
1. Suciedad Visible
El polvo y la pelusa son los enemigos cotidianos de cualquier hogar. Se acumulan en superficies y textiles, se eliminan eficazmente con una aspiradora potente y trapos de microfibra que atrapan las partículas de manera efectiva.
Las manchas, ya sean de comida, bebida o grasa, requieren diferentes enfoques de limpieza. Por ejemplo, el vino tinto se puede tratar con una solución de sal y agua con gas, mientras que las manchas de grasa pueden necesitar un quitamanchas enzimático específico.

¿cómo eliminar la suciedad visible y mantener la limpieza?
- Mantén una rutina diaria de limpieza utilizando aspiradoras con filtro HEPA y trapos de microfibra para una limpieza eficiente y sin dejar rastro.
- Trata las manchas con productos específicos siguiendo siempre las instrucciones del fabricante.
- Automatización de la Limpieza, la tecnología moderna ofrece soluciones como robots aspiradores y sistemas de limpieza programables que pueden ahorrar tiempo y esfuerzo.
2. Suciedad Microscópica
La suciedad microscópica comprende una amplia gama de organismos y partículas que no son visibles a simple vista pero afectan la salud; Estos incluyen ácaros, bacterias, virus, hongos y otros microorganismos que pueden causar alergias, enfermedades respiratorias e infecciones.
Ácaros: Los ácaros del polvo son pequeños artrópodos que se alimentan de escamas de piel humana y animal. Se encuentran comúnmente en colchones, almohadas, alfombras y tapicería. Para controlarlos se debe mantener un ambiente interior limpio y bien ventilado y lavar regularmente la ropa de cama y las cortinas con agua caliente.
Bacterias: Estos microorganismos unicelulares pueden encontrarse en una variedad de superficies del hogar y pueden causar enfermedades como gastroenteritis e infecciones respiratorias. Para combatir las bacterias, es fundamental mantener una buena higiene personal y de superficies, limpiando regularmente con desinfectantes adecuados.
Virus y Hongos: Los virus y los hongos también pueden encontrarse en el hogar y pueden causar una variedad de enfermedades. Para evitar su propagación, es importante mantener una buena ventilación y limpiar regularmente las superficies con desinfectantes y fungicidas adecuados.
¿cómo eliminar ácaros, bacterias, virus y hongos ?
- Desinfecta las superficies con lejía, limpiadores a base de alcohol o vinagre, especialmente en áreas propensas a la acumulación de bacterias como la cocina y el baño.
- Controla la humedad con deshumidificadores o ventilación adecuada para prevenir el crecimiento de ácaros y moho.
3. Suciedad Incrustada
La suciedad incrustada puede presentarse en forma de sarro o grasa, cada una requiriendo un enfoque específico para su eliminación.
Sarro: Es una acumulación de sales minerales, principalmente carbonato de calcio, que se forma en superficies expuestas al agua dura. Se encuentra comúnmente en grifos, duchas, baldosas y otros accesorios de baño y cocina. Para eliminarlo, se recomienda utilizar productos específicos diseñados para combatir la cal, como los limpiadores que contienen ácidos fuertes como el clorhídrico utilizados en limpieza pesada y ácidos débiles como el cítrico para limpieza suave o de mantenimiento.
Grasa: Se acumula en superficies como encimeras, estufas, campanas extractoras y utensilios de cocina. Para eliminarla, es fundamental utilizar desengrasantes potentes, ya sea comerciales que contengan hidróxido de sodio o potasio y caseros como el bicarbonato de sodio.

Emplea limpiadores ácidos para eliminar depósitos de cal en grifos y duchas, y desengrasantes para cocinas.
Enlaces útiles
Para aprender más sobre productos de limpieza ecológicos y métodos de limpieza efectivos, te recomendamos consultar:
- Guía de limpieza y desinfección en el hogar.
- Desinfectar un Baño. ¿ Qué es lo mejor?.
- Haz Tu Propio Desinfectante En Casa. Agua Electrolizada.
La limpieza doméstica es esencial para mantener un hogar limpio y saludable. Implementando las estrategias adecuadas y utilizando los productos correctos, podrás vencer cualquier tipo de suciedad.

